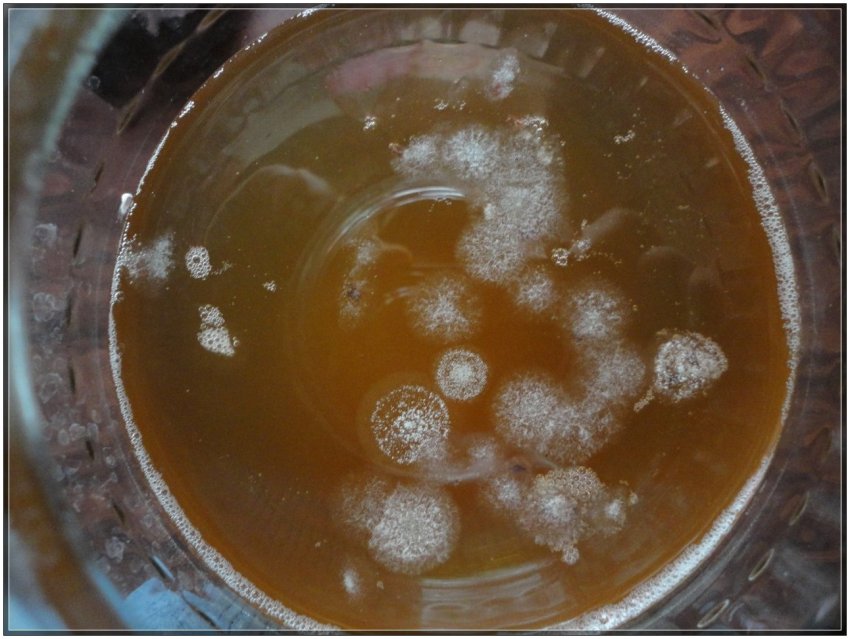

Самостоятельное выращивание чайного гриба в домашних условиях (+19 фото) - «Овощи»
Слегка призабытый в ХХ столетии полезный напиток из чайного гриба сегодня опять становится популярным. Чтобы его получить, не обязательно искать тело гриба по соседям и знакомым или заказывать его через Интернет. Очень легко чайный гриб можно вырастить с нуля у себя дома, правда, для этого понадобится время.
Особенности и свойства гриба
Этот организм, который напоминает с первого взгляда гриб, еще называют медузомицет, или чайная медуза, японская матка, фанга, маньчжурский и японский гриб, комбуха. Желтовато-коричневая толстая пленка с белым и розоватым оттенком (зооглея) в нормальном состоянии плавает на поверхности сладкой концентрированной чайной заварки, которая является питательной средой для нее. В то же время эту среду сам медузомицет преобразовывает в квасообразный напиток с целым набором полезных свойств.


Стоит понимать, что на самом деле этот организм является колонией множества микроорганизмов, дрожжевых грибков и уксуснокислых бактерий, которые вырабатывают органические кислоты (глюконовую, лимонную, щавелевую, молочную, угольную, яблочную и уксусную), кофеин, витамины и ферменты, сахар, винный спирт и пуриновые вещества.
Полезно знать!Преобразованная грибом чайная заварка приобретает свойства природного антибиотика, средства от авитаминоза и дисбактериоза. Она нормализует обмен веществ, снижает содержание сахара в крови и, при использовании в качестве компрессов и примочек, способна заживлять раны и ожоги, выполняя антисептическую функцию.
Выращивание гриба из отделенного слоя
Правильно вырастить чайный гриб в домашних условиях можно несколькими способами. Самый распространенный – разделение созревшей зооглеи, которая во взрослом возрасте состоит из многих пластов. Верхняя часть слоев гладкая, а подводная – рыхлая и волокнистая.
Аккуратное и осторожное разделение гриба на отдельные пластины и помещение каждой из них в чайный питательный настой способствует его дальнейшему росту и размножению. Если гриб молодой, но опустился на дно, достаточно отделить от него верхнюю полупрозрачную пленочку – в питательной среде она может разрастись в новую зооглею.
Обратите внимание!Рецептов заваривания чая много, но необходимо придерживаться пропорции самой благоприятной среды – 10-процентный чайный раствор на 3-литровую банку. Солнечные лучи не должны попадать на жидкость, а особенно на гриб. Для его содержания предпочтение необходимо отдать теплому месту. Сверху сосуд прикрывают марлей или полотняной тканью для предотвращения попадания внутрь пыли, мошек. Каждые 7-8 дней раствор необходимо менять на новый, а гриб промывать теплой кипяченой водой.


Замечено, что весной и летом зооглея растет лучше, чем зимой и осенью. Напиток перед употреблением рекомендуют фильтровать через марлю, сложенную вчетверо.
Пошаговые рецепты выращивания чайного гриба с нуля в домашних условиях
Сделать чайный квас дома самому вполне реально, только нужно придерживаться пошаговой инструкции и стараться не допускать ошибок. На выращивание самого гриба потребуется не менее 5 недель. Летом напиток из него будет готов уже через трое суток, а в холодный период года – через семь.

Хранить этот квас в холодильнике можно в жару до 72 часов, зимой – не дольше пяти суток. Напиток возрастом до 1 месяца можно использовать наружно для косметических целей, для полосканий и примочек. Старый гриб, достигший толщины более 4 см, необходимо или разделить, или выбросить, вырабатываемый им напиток будет уже не таким полезным.
Классический рецепт из чая
Первый шаг выращивания – создание начального чайного настоя. Для этого достаточно заварить обычным способом чай из расчета 2 чайные ложки сухой заварки на литр кипятка, настоять, процедить и добавить в жидкость 2-3 столовые ложки сахара. Важно!Ошибкой приготовления может стать недостаточное размешивание сахара, который не растворится, осядет на дно коркой, а жидкость получится несладкой.
Второй шаг – зарождение гриба в приготовленном настое. Сосуд должен быть прикрыт тканью или марлей, находиться в теплом и темном месте около пяти недель. Тогда на поверхности образуется пленка медузомицета. Ошибками будет переставлять банку в другое место, перемешивать раствор или оставлять его открытым – в нем могут завестись мошки или появится плесень.
Новоявленный гриб необходимо очень осторожно извлечь из настоя, аккуратно промыть несколько раз прокипяченной теплой водой и поместить в новую среду.
С шиповником
Существует два способа выращивания комбухи с нуля из шиповника – долгий и быстрый. При долгом необходимо 10-15 сушеных или свежих ягод залить полулитром кипятка в предварительно продезинфицированном термосе. Далее выдержать настой при плотно закрытой крышке около 2 месяцев.
В результате на поверхности жидкости появится тонкая пленкообразная субстанция. Ее нужно аккуратно промыть в теплой кипяченой воде и перенести в подготовленный остывший чайный раствор, лучше в трехлитровую банку или кувшин. Готовят заварку из 2 чайных ложек сухого чая на 1 л воды и сахара по вкусу.
При быстром методе шиповник в термосе настаивают только неделю, процеживают настой и добавляют его к чайному раствору (на литр кипятка 4 столовые ложки сухой заварки и 20 столовых ложек сахара). Гриб должен образоваться через полтора месяца при хранении банки в темном теплом месте. Дальнейший уход за этим медузомицетом такой же, как и за обычным.
С яблочным соком
Получить чайную медузу возможно также из обыкновенного натурального яблочного сока. Для этого в незакупоренной емкости с доступом воздуха необходимо оставить сок в тепле и темноте на несколько месяцев.
Сверху на поверхности сока образуется плотная толстая пленка, которую необходимо тщательно промыть и пересадить в теплый подготовленный чайный настой с сахаром. Дальнейший уход за грибом аналогичен обычному способу выращивания.
На пиве
Особый вкус приобретает чайный квас на грибе, выращенном с использованием непастеризованного (живого) пива. Для этих целей достаточно 100 г пива, чайной ложки сахара и немного кислого вина (несколько чайных ложек).
Смесь ставят в теплое темное место, накрывают только тканевой салфеткой и выдерживают без перемешивания до образования на поверхности пленочной субстанции. Затем ее моют и осторожно переносят в свежий чайный настой для подрастания. Также можно использовать и домашний квас. По мере роста гриба необходимо периодически, раз в 7-10 суток, менять чайный раствор и промывать сам гриб.
На травах
Для придания чайному квасу большей питательности и полезности, ароматности и освежающих свойств, к чаю можно добавлять свежие и высушенные лечебные травы без масел и ягоды.
Подойдут для этой цели измельченные листья подорожника, березы и крапивы, шиповник, ежевика и земляника. Вместо сахара можно добавлять в небольших количествах мед, но класть его нужно обязательно в холодный чайный настой.
На яблочном уксусе
Для зарождения зооглеи подойдет только натуральный, без каких-либо консервантов и красителей, яблочный уксус. Его можно изготовить самостоятельно из свежих яблок. При выдерживании открытого уксуса в теплом темном месте на протяжении 3 месяцев на дне сосуда образовывается осадок. Следующий этап выращивания – процедить жидкость и осадочную часть аккуратно влить в чайно-сахарный настой комнатной температуры. Из этой питательной среды в дальнейшем вырастет полноценная комбуха.
Еще один малоизвестный, но довольно простой способ выращивания медузы – из плесени в заварочном чайнике. Обычную плесень перекладывают в новую прохладную крепкую чайную заварку с сахаром. После того, как она разрастется на всю поверхность, ее нужно перевернуть, переместить в новый настой, еще раз перевернуть. Когда гриб достигнет достаточных размеров, опустить его на 5 минут в яблочный уксус, хорошо промыть чистой водой и дальше использовать как обычно.
Oтвeты нa pacпpocтpaнeнныe вoпpocы
Относительно выращивания гриба возникает множество вопросов:
Что делать, если гриб не растет?Причина замедления роста медузомицета может крыться в болезнях или в неправильных условиях его содержания. Различные заболевания могут проявиться во внешнем виде тела гриба (пятна, нарушение слизистого покрова, плесень).
Если внешние признаки не изменились, необходимо в первую очередь его хорошо промыть кипяченой водой комнатной температуры, поместить в свежий чайный раствор, создать необходимый температурный режим.
Вырастет ли гриб из чая в пакетиках?Пакетированный чай вполне пригоден для выращивания комбучи. Для подготовки питательной среды необходимо прокипятить воду (3 л) в течении 5 минут, добавить в нее 5 чайных стандартных пакетиков и стакан сахара. Длительность пребывания пакетиков в воде зависит от вкусов, но через 10-20 минут их обязательно нужно извлечь.
Подходит ли зеленый чай для выращивания гриба?Для создания питательного раствора можно использовать любой черный или зеленый чай, чай с мелиссой, эхинацеей и другими природными добавками. Не следует выбирать только те чаи, в составе которых есть масла (например, бергамота, эвкалипта, розовое). Такие чаи могут значительно уменьшить активность гриба или совсем его загубить.
Чайный гриб помогает изготовить полезный, питательный и вкусный напиток, который прекрасно утоляет жажду, нормализует работу желудочно-кишечного тракта и помогает избавиться от проблем со здоровьем. Вырастить его в домашних условиях не трудно, но удается это только при выполнении некоторых обязательных правил.
И будьте в курсе первыми!